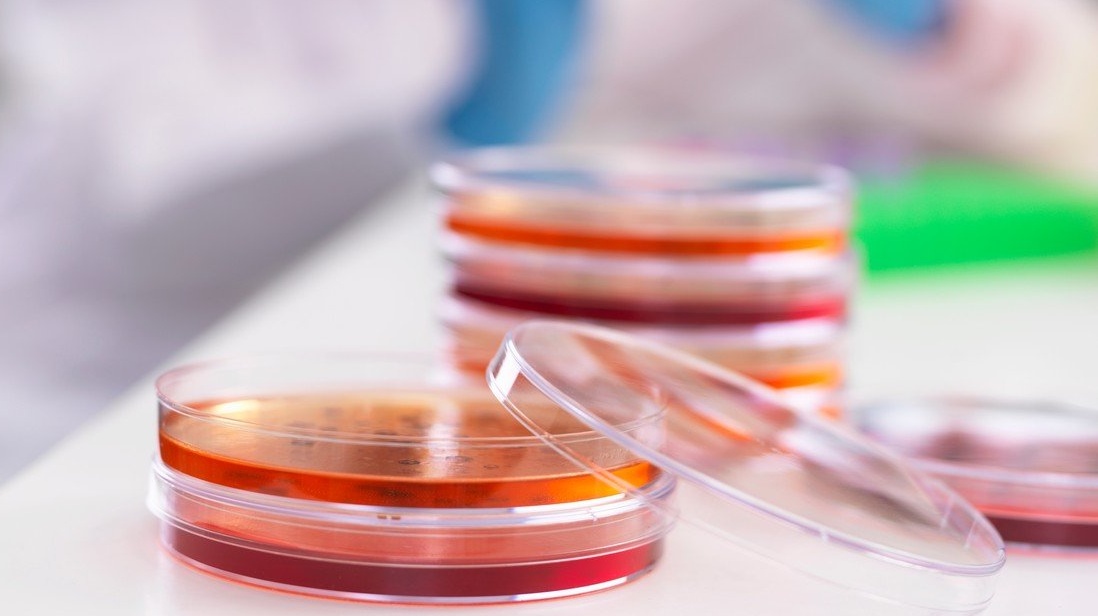
Nový test odhalí všechny známé bakteriální infekce najednou

Články s tagem: nemoci a nákazy
Magazín
Kouří veřejně marihuanu a ještě jí za to platí
11. 5. 2019
|
Lenka Dvořáčková
Gratulujeme, stala jste se naším dvorním huličem! Když se Kayla Gerberová zprávu, byť jistě sdělenou trochu solidnějšími slovy, dozvěděla, skákala a křičela radostí. Získala práci snů nejednoho konzumenta marihuany – stala se jednou z osmi placených znalců konopí.
Člověk
Nový lék zabraňuje přenosu viru HIV pohlavním stykem
8. 5. 2019
|
Ladislav Loukota
Virus HIV je v poslední době stále více v defenzivě. Před dvěma měsíci byla potvrzena funkčnost experimentální (ačkoliv momentálně také vysoce nepraktické a rizikové) metody eliminace viru HIV pomocí transplantaci kostní dřeně. Vypadalo to jako významný pokrok. Na ten významnější však došlo minulý týden díky dvěma studiím zkoumajícím efektivitu nejmodernějších antivirotik bojujících s HIV. Ačkoliv ani jeden z léků přímo neeliminoval virus, výsledek jejich činnosti se blíží efektu téhož. A co je nejpodstatnější, na rozdíl od transplantace kostní dřeně se tyto léky mohou dostat k milionům potřebných lidí.
Člověk
Máte strach ze zubaře? Možná jste ho zdědili po rodičích, ukazuje studie
6. 5. 2019
|
Pavel Pešek
Pololežíte v zubařském křesle. Čelisti držíte nepřirozeně otevřené, aby do nich zubař dobře viděl. Dolní patro vám dráždí odsávačka. K dásni se blíží injekce a po ní bude následovat protivné bzučení zubní vrtačky nebo trhání zubů kleštěmi. Přijde vám taková představa děsivá natolik, že odkládáte návštěvu zubaře, co nejdéle je to možné? Možná jste tento strach zdědili po svých předcích.
Člověk
Voda dětem nic neříká, jedno z pěti ji vůbec nepije, zjistila studie v USA
2. 5. 2019
|
Ladislav Loukota
Pijete správné tekutiny a v dostatečném množství? Podle posledních údajů je lidí jako vy nejspíše stále méně. Až 20 procent amerických dětí totiž zcela ignoruje příjem vody. Namísto toho holdují především slazeným nápojům. Vystavují se tak ovšem podstatně zvýšenému riziku rozvoje cukrovky a obezity.
Člověk
Lidé si vybírají partnery s podobným zdravím, jaké mají oni sami
19. 4. 2019
|
Ladislav Loukota
Myslíte, že existuje láska na první pohled? Podle poslední vědecké studie možná ano - zdá se totiž, že celoživotní páry mají statisticky významnou tendenci hledat jeden druhého podle svých zdravotních rizik. Než však začnete toto zjištění interpretovat jako existenci jakéhosi "šestého smyslu", ještě raději počkejte. Práce totiž sama zmiňuje, že odhalila jenom statistickou korelaci. Také tedy může být další dokonalou ilustrací dilematu mezi tím, zdali bylo první vejce anebo slepice.
Člověk
S pandemií pravých neštovic bychom bojovali deset let
27. 2. 2019
|
Ladislav Loukota
Plané neštovice jsou dnes středně vážnou dětskou chorobou. Nebylo tomu tak ale vždy. Do druhé poloviny 20. století byly pravé neštovice nemocí, která hubila lidi po milionech. Přítrž tomu udělala až velká vakcinační kampaň v 60. letech. Co kdyby se však pravé neštovice vrátily? Podle nové studie by byly ohrožením pro celou další generaci.
Člověk
Jediný lék úspěšně léčí šest různých typů nádorů
13. 2. 2019
|
Ladislav Loukota
Výzkumníci mu přezdívají "trojský kůň", nová testovaná látka totiž dovede zevnitř zasáhnout nádorové buňky, a co je podstatnější, funguje proti více druhům rakoviny najednou. Hned zkraje se ale sluší zmínit, že zdaleka nejde o univerzální lék se stoprocentní účinností – očekávat něco takového by v případě zákeřných nádorových onemocnění totiž zavánělo notnou naivitou. Proč tedy novinka přesto dává důvod k optimismu?
Člověk
Nový test odhalí všechny známé bakteriální infekce najednou
13. 11. 2018
|
Ladislav Loukota
Píše se sice 21. století, otrava krve alias sepse je však i dnes platí za překvapivě nebezpečné onemocnění. Až třetina pacientů, která zánět dostane, v důsledku choroby umírá. Typickou formou léčby jsou antibiotika, aby však na jejich nasazení došlo, musí být nemoc nejprve správně diagnostikována. Právě to by nyní mohl výrazně ulehčit nový krevní test schopný odhalit najednou prakticky všechny známé bakteriální infekce.